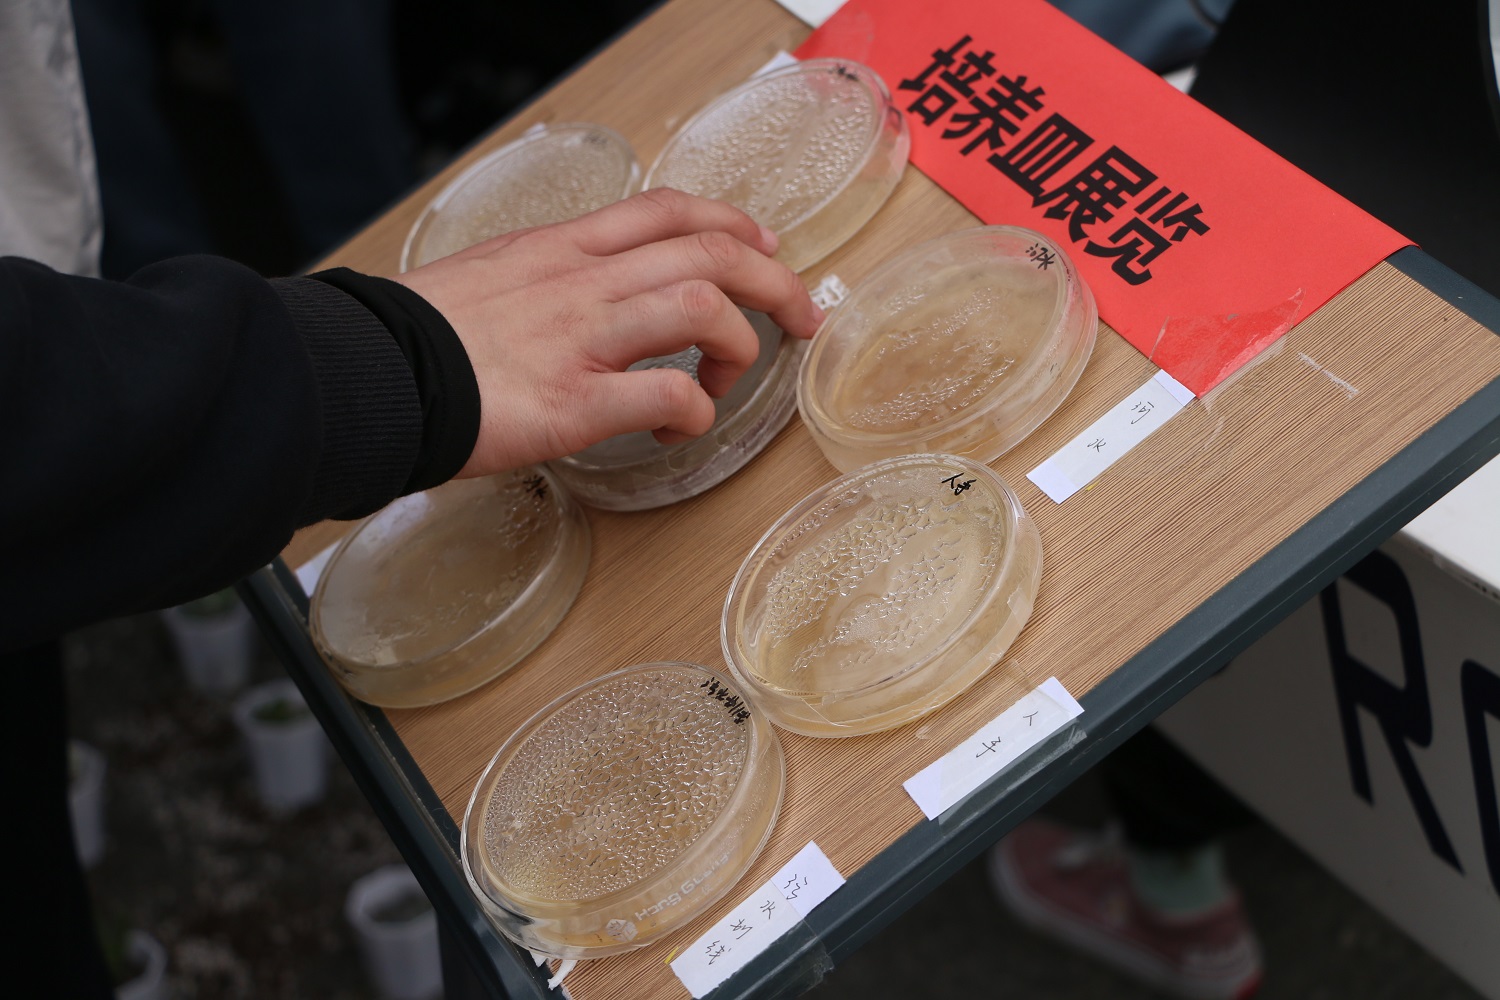

悠悠岁月,芳华永存;七十二载,薪火相传。在中国共产党成立100周年这个特殊年份,大工72周年校庆恰逢其时。为增强校区广大青年爱党爱校情怀,传承红色基因,校区团工委于4月11日组织开展“七彩青春迎校庆 建党百年绽芳华”校园文化节系列活动,上千名校区学子积极参与,纷纷用青春方式为大工献上最独特的生日祝福,用别样的青春风采为建党100周年献礼。


温情寄语
在凌水河畔放下一盏河灯,在明信片上绘制校园风景,在便利贴上写下祝福寄语,在蜡笔之下描摹玉兰盛开……在祝福展示区,同学们用一笔一画,勾勒出理工人的专属浪漫;用斑斓色彩,描绘着对未来的美好期盼;用片片红心,倾诉着爱党爱校的情怀。






青春飞扬
72个七彩摊位,精彩纷呈的趣味活动,所行之处,尽洋溢欢庆氛围。同学们在书法社感受翰墨书香,在美术社体验手创的快乐,在国风社品味古代投壶风韵,在音乐社欣赏旋律的悦动……学院组成的摊位也尽显特色,将专业知识寓教于乐,巧妙实现了文化与创新的融合。岁岁光阴,代代延续,铸就了最好的大工,也铸就了最好的新时代青年。

舞动年华
中午12点,舞台表演准时开场。乐队激情的歌声将青春的热度点燃;啦啦操社、漫研社和国风社的舞步闪耀着活力的光彩;星团独唱《那些年》将青涩的回忆娓娓道来;《武魂》舞刀弄枪间是铿锵绽放的英姿慷慨。同学们纷纷驻足台前,或跟着节奏摇摆,或高声热烈喝彩,全场气氛达到高潮。





时代画笔,勾勒七十二载风云;岁月灯盏,照耀一百年荣光。以七十二载红色传承,同庆建党百年,校区青年用七彩青春向党和大工深情献礼,沉浸式的校情校史学习也让校区学子更深刻体悟大工底蕴、践行红色基因。愿校区青年在大工新的一岁,砥砺前行担使命,持续奋斗守初心,星河滚烫逐理想,奋勇争先添荣光!